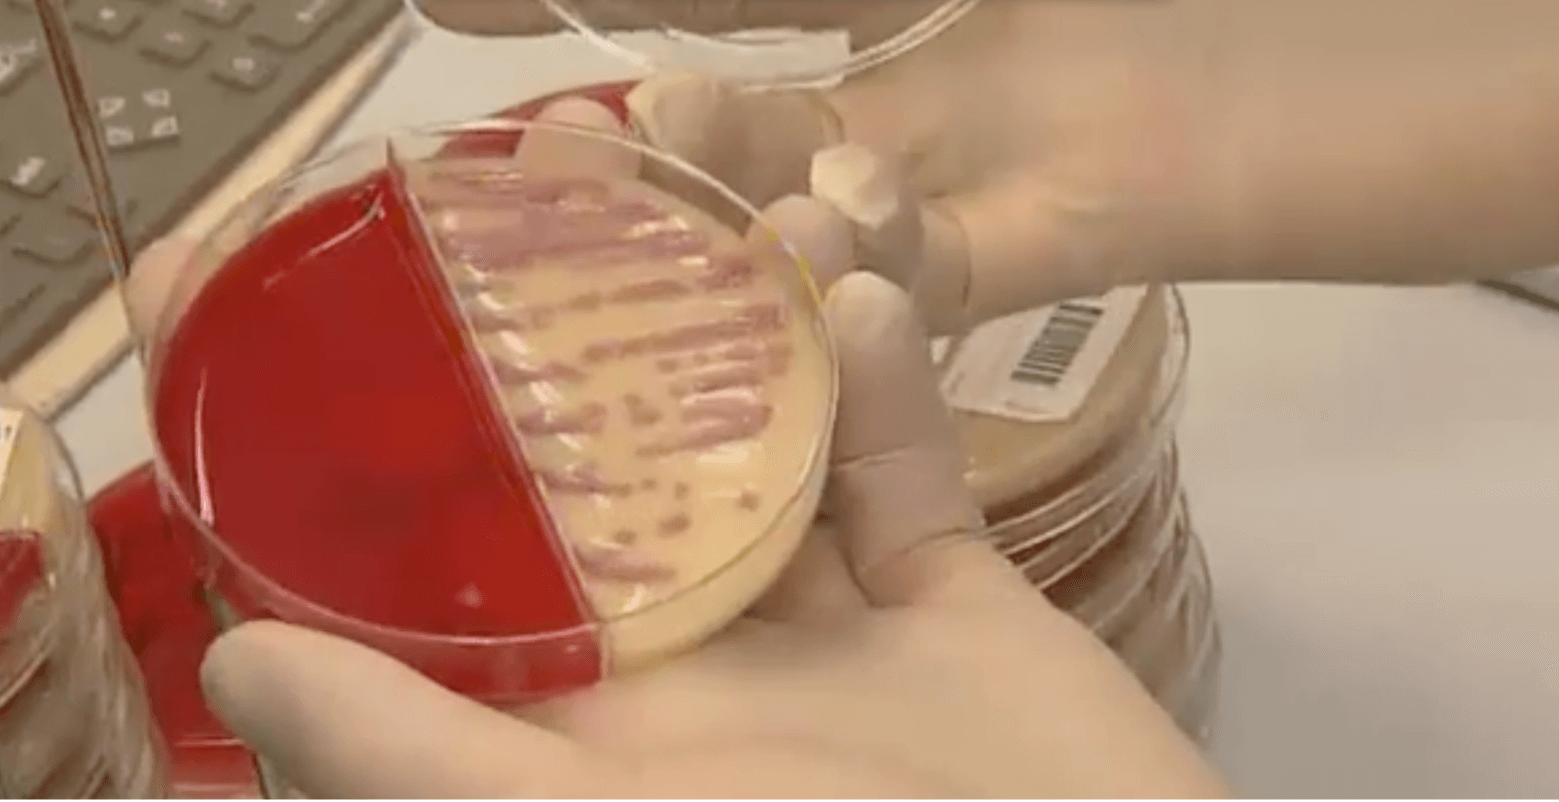
picture of the news

“Life can change in an instant”

Botulism Survivor Story Showcases the Real-World Importance of MedicalCountermeasures
Live people hospitalised in France with suspected botulism linked to pesto sauce in France



